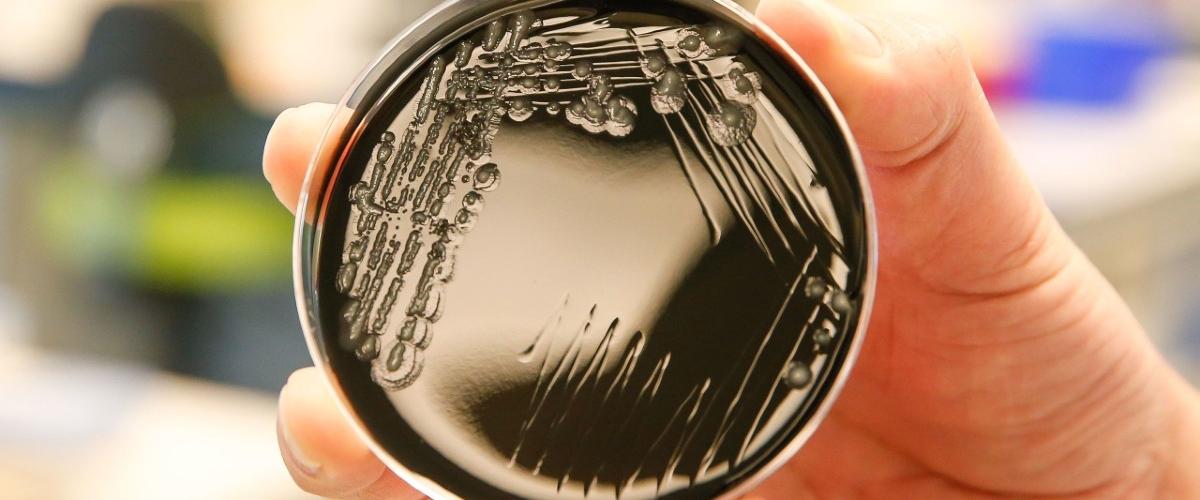
TODO:

Болезнь Легионеров представляет собой тяжелую инфекцию, которая развивается из-за вдыхания аэрозолей или проникновения возбудителя, бактерии Legionella, через питьевую воду. Техническое обслуживание и мониторинг систем водоснабжения являются важной мерой профилактики болезни. Теперь благодаря открытию, которое сделали ученые из Австралии, появляется возможность значительно усилить контроль за патогеном.
Команда из Университета Флиндерса выяснила, что бактерии Legionella заражают амебу-хозяина, и оказавшись внутри нее оказываются защищенными от стратегий дезинфекции, пишет Science Daily.
Это первый случай, когда амебы Allovahlkampfia и Stenamoeba были обнаружены хозяевами легионелл. Согласно полученным результатам, до 75% образцов питьевой воды или биопленки, тестируемые в рамках исследования, дали положительный результат на наличие амеб. Пробы взяли из душевых леек и кранов в жилых домах и больницах в Австралии.
«Понимание взаимосвязей между амебами и легионеллами является важным шагом в улучшении методов очистки воды для предотвращения инфицирования», — прокомментировала соавтор работы Хэриэтт Уилли. Дальнейшие исследования будут направлены на их разработку и тестирование.
Помимо патогенов питьевая вода содержит частицы микропластика, которые также попадают в организм человека. Недавно корейские ученые представили технологию, которая очищает воду от пластиковых частиц на 99,99% за десять секунд.